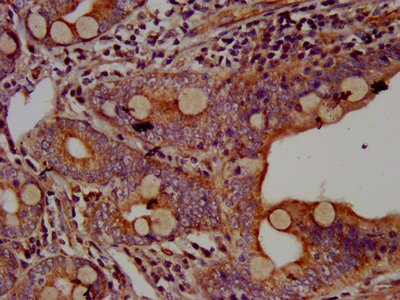

AHNAK Antibody
-
中文名稱:AHNAK兔多克隆抗體
-
貨號:CSB-PA600257LA01HU
-
規格:¥440
-
圖片:
-
IHC image of CSB-PA600257LA01HU diluted at 1:500 and staining in paraffin-embedded human small intestine tissue performed on a Leica BondTM system. After dewaxing and hydration, antigen retrieval was mediated by high pressure in a citrate buffer (pH 6.0). Section was blocked with 10% normal goat serum 30min at RT. Then primary antibody (1% BSA) was incubated at 4°C overnight. The primary is detected by a biotinylated secondary antibody and visualized using an HRP conjugated SP system.
-
IHC image of CSB-PA600257LA01HU diluted at 1:500 and staining in paraffin-embedded human heart tissue performed on a Leica BondTM system. After dewaxing and hydration, antigen retrieval was mediated by high pressure in a citrate buffer (pH 6.0). Section was blocked with 10% normal goat serum 30min at RT. Then primary antibody (1% BSA) was incubated at 4°C overnight. The primary is detected by a biotinylated secondary antibody and visualized using an HRP conjugated SP system.
-
Immunofluorescence staining of Hela cells with CSB-PA600257LA01HU at 1:166, counter-stained with DAPI. The cells were fixed in 4% formaldehyde, permeabilized using 0.2% Triton X-100 and blocked in 10% normal Goat Serum. The cells were then incubated with the antibody overnight at 4°C. The secondary antibody was Alexa Fluor 488-congugated AffiniPure Goat Anti-Rabbit IgG(H+L).
-
-
其他:
產品詳情
-
產品名稱:Rabbit anti-Homo sapiens (Human) AHNAK Polyclonal antibody
-
Uniprot No.:
-
基因名:
-
別名:AHNAK antibody; AHNAK nucleoprotein (desmoyokin) antibody; AHNAK nucleoprotein antibody; AHNAKRS antibody; AHNK_HUMAN antibody; Desmoyokin antibody; Fragments antibody; MGC5395 antibody; Neuroblast differentiation associated protein AHNAK antibody; Neuroblast differentiation-associated protein AHNAK antibody; PM227 antibody
-
宿主:Rabbit
-
反應種屬:Human
-
免疫原:Recombinant Human Neuroblast differentiation-associated protein AHNAK protein (5689-5801AA)
-
免疫原種屬:Homo sapiens (Human)
-
標記方式:Non-conjugated
本頁面中的產品,AHNAK Antibody (CSB-PA600257LA01HU),的標記方式是Non-conjugated。對于AHNAK Antibody,我們還提供其他標記。見下表:
-
克隆類型:Polyclonal
-
抗體亞型:IgG
-
純化方式:>95%, Protein G purified
-
濃度:It differs from different batches. Please contact us to confirm it.
-
保存緩沖液:Preservative: 0.03% Proclin 300
Constituents: 50% Glycerol, 0.01M PBS, pH 7.4 -
產品提供形式:Liquid
-
應用范圍:ELISA, IHC, IF
-
推薦稀釋比:
Application Recommended Dilution IHC 1:500-1:1000 IF 1:50-1:200 -
Protocols:
-
儲存條件:Upon receipt, store at -20°C or -80°C. Avoid repeated freeze.
-
貨期:Basically, we can dispatch the products out in 1-3 working days after receiving your orders. Delivery time maybe differs from different purchasing way or location, please kindly consult your local distributors for specific delivery time.
-
用途:For Research Use Only. Not for use in diagnostic or therapeutic procedures.
相關產品
靶點詳情
-
功能:May be required for neuronal cell differentiation.
-
基因功能參考文獻:
- These findings confirm that AHNAK functions in the chemotherapeutic response of breast cancer cells while also emphasizing the need for further investigation into potential implications for AHNAK in terms of predicting and modulating treatment response. PMID: 29309757
- our results suggest that AHNAK acts as a tumor suppressor that negatively regulates TNBC cell proliferation, TNBC xenograft growth and metastasis via different signaling pathways. PMID: 28494797
- AHNAK enables mammary carcinoma cells to produce and release extracellular vesicles that cause disruption of the stroma by surrounding fibroblasts PMID: 27374178
- Based on the findings, the authors designate the Chlamydia trachomatis gene product corresponding to ct694-ctl0063translocated membrane-associated effector A (TmeA). Overall, the data reveal a role of TmeA during chlamydial invasion that manifests independently of effects on AHNAK. PMID: 28970272
- Examination of Gene Expression Omnibus database data sets suggests that downregulation of AHNAK mRNA and mutation of the AHNAK gene are common in metastatic melanoma and correlates to a poor outcome. PMID: 26672724
- inhibition of Ahnak can promote generation of induced pluripotent stem cells (iPSC) via up-regulation of endogenous c-Myc. PMID: 26598518
- tetrandrine may inhibit the growth of Hep-2 cells by decreasing the intracellular concentration of Ca2+ and upregulating the expressions of Brg1 and AHNAK PMID: 26642721
- Authors show here that AnxA2, p11 and AHNAK are required for type 3 secretion system-mediated Salmonella invasion of cultured epithelial cells. PMID: 23931152
- High AHNAK expression is asociated with mesothelioma. PMID: 24253341
- novel strategies for an accurate prognosis in larynx carcinoma and suggest potential mechanisms of inflammation-mediated tumor progression PMID: 23409183
- While the structure-based consensus sequence allows interactions with various stretches of the AHNAK C-terminal domain, comparison with other S100 structures reveals that the sequence has been optimized for binding to S100A10. PMID: 23275167
- The AHNAK peptide adopts a coil conformation that arches across the heterotetramer contacting both annexin A2 and S100A10 protomers with tight affinity. PMID: 22940583
- these results define ahnak1 in muscle connective tissue as a novel feature of two genetically distinct muscular dystrophies that might contribute to disease pathology. PMID: 22057634
- AHNAK constitutes a novel mechanism in post-transcriptional control of gene expression. PMID: 21940993
- Multiple titin antibodies, particularly those recognizing the PEVK region, cross-react with AHNAK. PMID: 11746675
- he carboxyl-terminal region of ahnak provides a link between cardiac L-type Ca2+ channels and the actin-based cytoskeleton PMID: 12153988
- The carboxyl-terminal ahnak domain exerts a stabilizing effect on muscle contractility via its interaction with actin of thin filaments. PMID: 15001564
- AHNAK mediates activation of phospholipase C-gamma1 through protein kinase C PMID: 15033986
- Ahnak has a critical role in cardiac Ca(V)1.2 calcium channel function and its beta-adrenergic regulation PMID: 16319140
- A study demonstrating that Annexin2 is required for strong binding of S100A10 to the C-terminal domain of the protein Ahnak. PMID: 16984913
- AHNAK accumulates when calpain 3 is defective in skeletal muscle of calpainopathy patients; moreover, AHNAK fragments cleaved by CAPN3 have lost their affinity for dysferlin. PMID: 18334579
顯示更多
收起更多
-
亞細胞定位:Nucleus.
-
數據庫鏈接:
Most popular with customers
-
-
YWHAB Recombinant Monoclonal Antibody
Applications: ELISA, WB, IHC, IF, FC
Species Reactivity: Human, Mouse, Rat
-
Phospho-YAP1 (S127) Recombinant Monoclonal Antibody
Applications: ELISA, WB, IHC
Species Reactivity: Human
-
-
-
-
-